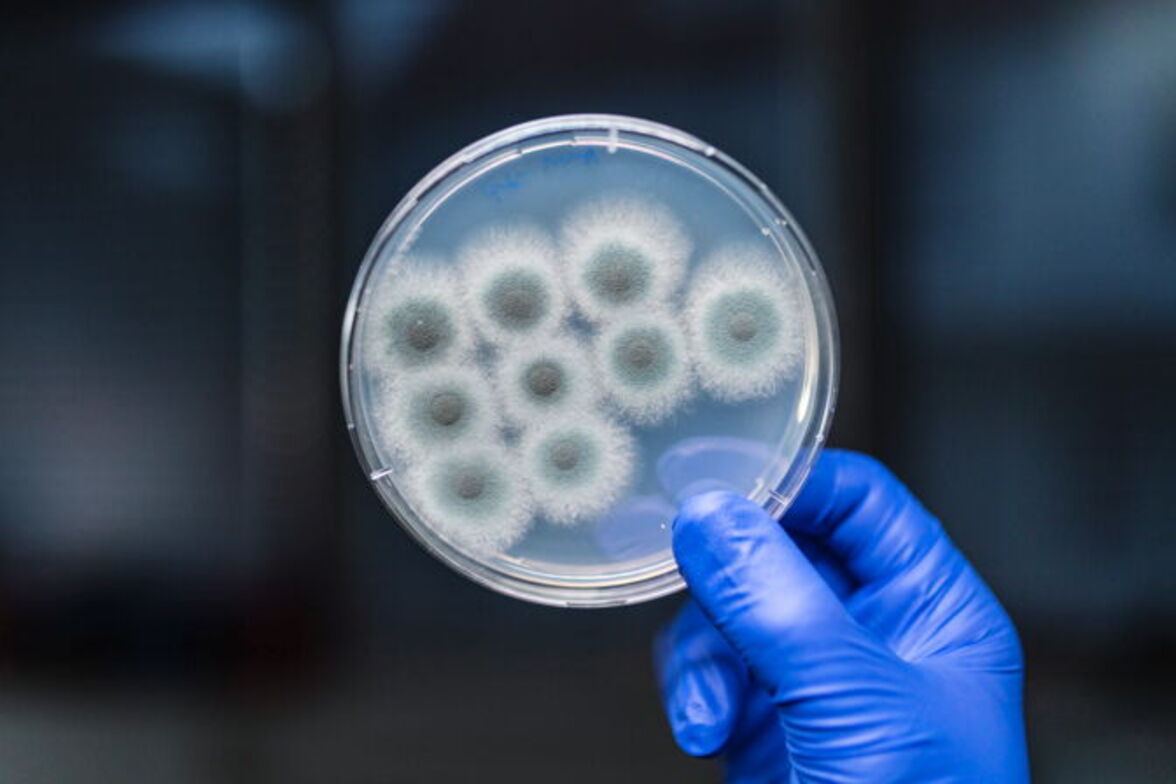
Грибковые патогены процветают в тени пандемии

В новом списке грибковых "приоритетных патогенов" ВОЗ выделяет 19 из этих часто упускаемых из виду микроорганизмов, представляющих наибольшую угрозу для здоровья человека.
В докладе, опубликованном вчера (25 октября), подчеркивается, что "грибковые инфекции растут и становятся все более резистентными к лечению, превращаясь в проблему общественного здравоохранения во всем мире", - говорится в заявлении Ханана Балхи, заместителя Генерального директора ВОЗ по вопросам резистентности к противомикробным препаратам. Ранее организация составляла аналогичные списки для вирусов и бактерий.
По оценкам, ежегодно регистрируется более 150 миллионов тяжелых грибковых инфекций, что приводит к смерти примерно 1,7 миллиона человек. Однако эти цифры основаны на неполных данных, поэтому доклад "призван сфокусировать и стимулировать дальнейшие исследования и политические меры для усиления глобального ответа на грибковые инфекции и противогрибковую резистентность". Так, грибковые инфекции в настоящее время получают менее 1,5 % от общего объема финансирования исследований в области инфекционных заболеваний, отмечают авторы. Джастин Бердсли из Института инфекционных болезней Сиднейского университета, возглавлявший группу по заказу ВОЗ, которая помогала в составлении отчета, заявил, что уровень финансирования неоправданно низок, учитывая "огромное бремя заболеваний", вызываемых грибковыми инфекциями. "Они вызывают столько же смертей, сколько туберкулез, и больше, чем малярия". По данным ВОЗ, в 2020 году эти заболевания стали причиной смерти примерно 1,5 миллиона и 627 000 человек соответственно.
Всего в списке выделено 19 патогенов, каждый из которых отнесен к категории среднего, высокого или критического приоритета на основании их потенциального влияния на здоровье человека и того, что известно об их резистентности к противогрибковым препаратам. Четыре патогена были отнесены к критической категории: Cryptococcus neoformans, оппортунистический патоген, который является основной причиной смерти людей с ВИЧ; Candida auris, грибок, вызывающий инфекции с высоким уровнем смертности и уже вызвавший множество вспышек в стационарах; Aspergillus fumigatus, вездесущая плесень с появляющейся резистентностью к азольным противогрибковым препаратам; и Candida albicans, грибок, распространенный в микробиоме здорового человека, который также может вызывать молочницу и опасные для жизни инфекции кровотока.
Согласно отчету, некоторые патогены попали в список из-за расширения их географического ареала, в то время как другие продемонстрировали рост распространенности инфекций, особенно во время пандемии COVID-19. Бердсли сообщил, что многие новые фармацевтические препараты для лечения заболеваний, включая COVID-19, непреднамеренно помогают патогенным грибкам, вмешиваясь в иммунные пути, участвующие в борьбе с грибковыми инфекциями, и в результате "мы наблюдаем внезапно на порядки больше грибковых инфекций, и это привлекает всеобщее внимание". A. fumigatus, например, получил широкое распространение как вторичная инфекция после SARS-CoV-2, вызывая заболевание, известное как COVID-ассоциированный легочный аспергиллез.
Многие из перечисленных грибков также вызывают тревогу из-за их появляющейся резистентности к противогрибковым препаратам - лекарствам, разнообразие которых и так ограничено из-за трудностей, связанных с воздействием на эукариотические патогены. В настоящее время существует всего четыре вида противогрибковых препаратов. В отличие от антибактериальных средств, противогрибковые препараты редко используются чрезмерно у людей; однако их применение в сельском хозяйстве и животноводстве способствует эволюции резистентности.
В докладе также изложены стратегии по развитию инфраструктуры и потенциала, необходимых для борьбы с грибковыми заболеваниями. "Нам необходимо больше данных и фактов о грибковых инфекциях и противогрибковой резистентности для информирования и улучшения ответных мер на эти приоритетные грибковые патогены", - говорит директор департамента ВОЗ по противомикробной резистентности Хайлиесус Гетахун в заявлении организации.
"Мы смогли так быстро отреагировать на COVID, потому что фундаментальная наука была готова", - отмечает Бердсли. "В течение десятилетий мы не инвестировали в фундаментальную науку в области микологии. Так что все начинается с нуля, и нам действительно нужно наверстать упущенное".